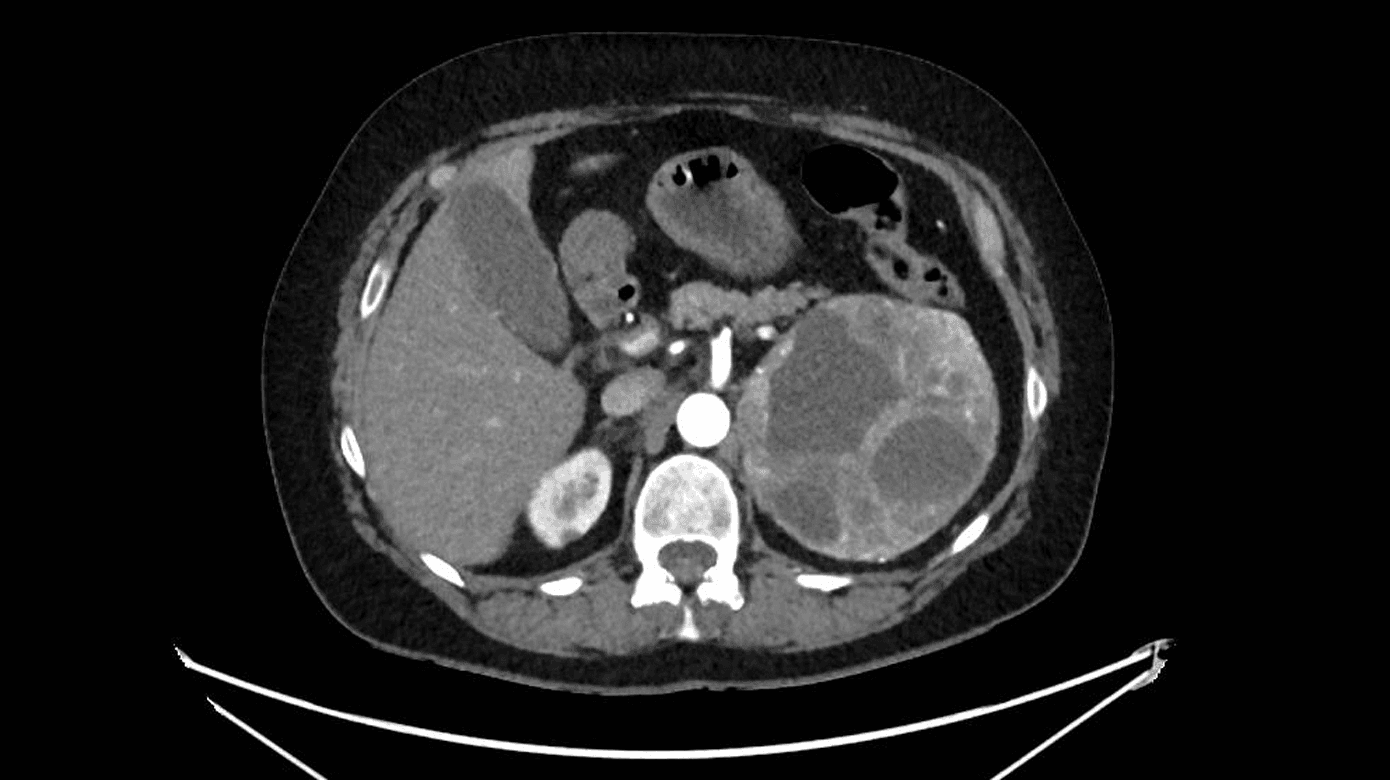
cover

Sjældent fund af fæokromocytom hos patient med højtrykslungeødem

Claes Falkenberg Elvander1, Sune Hansen2 & Jonas Sjøland3
Højtrykslungeødem ses hyppigt i akutmodtagelsen og kan repræsentere flere forskellige sygdomstilstande og underliggende diagnoser [1].
Patienterne behandles umiddelbart symptomatisk, indtil man kender den underliggende årsag til patientens lungeødem. Vi beskriver her en sygehistorie med højtrykslungeødem hos en tidligere hjerterask patient.
En 56-årig i det væsentligste sund og rask kvinde fik foretaget ukompliceret elektiv knæalloplastik pga. knæartrose. Ugen efter blev hun kortvarigt indlagt med infektion uden sikkert fokus, behandlet med piperacillin-tazobactam (pip/tazo). Hun havde normalt blodtryk ved udskrivelsen.
Patienten blev genindlagt få døgn senere som kritisk kald med pludseligt opstået, fulminant lungeødem med hypertension, et blodtryk på 230/120 mmHg og sinustakykardi 170/min. Patienten blev efter modtagelsen behandlet akut med i.v.-furosemidinjektioner, sublingval nitroglycerinspray og refrakte doser i.v.-fentanyl. Hun fik desuden continuous positive airway pressure (CPAP)-behandling, og pip/tazo-behandling blev genoptaget. Røntgen af thorax viste svære bilaterale infiltrater. Svælgpodning for SARS-CoV-2 var negativ.
Patienten visiteredes til intensiv terapi, hvor hun udviklede tiltagende multiorganpåvirkning med sløret sensorium, respirationsinsufficiens, cirkulatorisk svigt og vigende diureser. Ekkokardiografi viste svært nedsat venstre ventrikel-uddrivningsfraktion (LVEF) 20% uden tegn til højresidig belastning. CT af thorax og abdomen var uden lungeemboli. Som bifund fandtes en 11 cm stor tumor over venstre nyre (Figur 1). Efterfølgende blodprøver viste massivt forhøjede værdier af 3-methoxyadrenalin 452,5 nmol/l (referenceniveau: < 0,47 nmol/l [2]) og 3-methoxynoradrenalin 203,5 nmol/l (referenceniveau: < 1,10 nmol/l). Der kræves ingen patientforberedelse forud for prøvetagning [2].
Patienten behandledes aggressivt for sit endogene katekolaminspejl med bilevel positive airway pressure, nitroprussid og diuretika. Efter aftale med lokale landsdelscenter udtrappedes nitroprussid, mens labetalol som i.v. infusion blev iværksat. Patienten udviklede tiltagende kredsløbskollaps, dels betinget af behandlingen med labetalol, dels af hypovolæmi, vurderet ud fra ekkokardiografiske og klinisk præsentation. Labetalol blev seponeret, og der blev givet væskeboli. I de efterfølgende tre dage var patienten betydeligt vasopressor- og inotropikrævende med adrenalin, noradrenalin, dobutamin og dopamin. Fornyet ekkokardiografi viste skred i LVEF til 10-15%.
Patienten blev overflyttet til et intensivt sengeafsnit på det lokale landsdelscenter, og tilstanden stabiliserede sig de følgende dage. Vasopressor- og inotropistøtten kunne gradvist udfases. Der blev opstartet alfablokerende behandling med tablet phenoxybenzamin. LVEF normaliseredes, og patienten fik på 20.-dagen foretaget subakut laparoskopisk resektion af binyretumoren. Venstre nyre blev ligeledes reseceret pga. kommunikanter mellem nyren og tumoren. Postoperativt rettede patientens tilstand sig betydeligt og kunne udskrives velbefindende på 24.-dagen.
En patologisk undersøgelse af resektatet bekræftede diagnosen fæokromocytom.
Lungeødem kan have mange årsager, hvorunder kardielle faktorer er hyppige [1]. En bidragende fysiologisk mekanisme kan være sympathetic crashing acute pulmonary edema (SCAPE) – også kaldet »flash«-ødem, karakteriseret ved højt endogent katekolaminspejl medførende forhøjet pulmonaltryk, øget kapillærpermeabilitet og lokal frigivelse af inflammatoriske cytokiner [3].
Patientens fæokromocytom fremstod med akut opstået hypertensiv krise med lungeødem og akut katekolamininduceret hjertesvigt, som hurtigt forværredes til multiorgansvigt (centralnervesystem, nyre, lunger, hjerte). Præsentationsformen er tidligere beskrevet, men ikke i en dansk kontekst. Set i bakspejlet burde behandlingen sandsynligvis ikke være ændret til labetalolinfusion trods det massivt høje katekolaminspejl, da kombineret alfa- og betablokade kan have forværret det akutte hjertesvigt. Forsigtig alfablokade under intensiv overvågning havde været et bedre valg end labetalol.
Fæokromocytom er en sjælden årsag til lungeødem. Prævalensen for fæokromocytom hos hypertonikere er opgjort til 0,1-0,6% i en italiensk opgørelse, mens hypertensive kriser stod for ca. 3% af alle henvendelser i akutmodtagelsen [4, 5]. Diagnosen fæokromocytom bør haves i erindring ved anamnese med pludselig sværbehandlet hypertensiv krise.
Korrespondance Claes Falkenberg Elvander. E-mail: claes.falkenberg.elvander@rsyd.dk
Antaget 7. februar 2023
Publiceret på ugeskriftet.dk 10. april 2023
Interessekonflikter ingen. Forfatternes ICMJE-formularer er tilgængelige sammen med artiklen på ugeskriftet.dk
Referencer findes i artiklen publiceret på ugeskriftet.dk
Artikelreference Ugeskr Læger 2023;185:V11220700
Claes Falkenberg Elvander, Sune Hansen & Jonas Sjøland
Ugeskr Læger 2023;185:V11220700
In this case report, a 56-year-old woman presented to the emergency department with rapid onset dyspnoea, hypertension, tachycardia, hypoxaemia, and pulmonary oedema. A chest radiography revealed severe bilateral infiltrations and pulmonary oedema. Subsequent computertomography showed left-sided adrenal tumour and blood samples severely increased catecholamines. The patient received treatment including beta-blocking agents and developed severe heart failure. After stabilisation the patient underwent surgical resection of the tumour and left kidney. Pathological assessment revealed the diagnosis of pheochromocytoma.